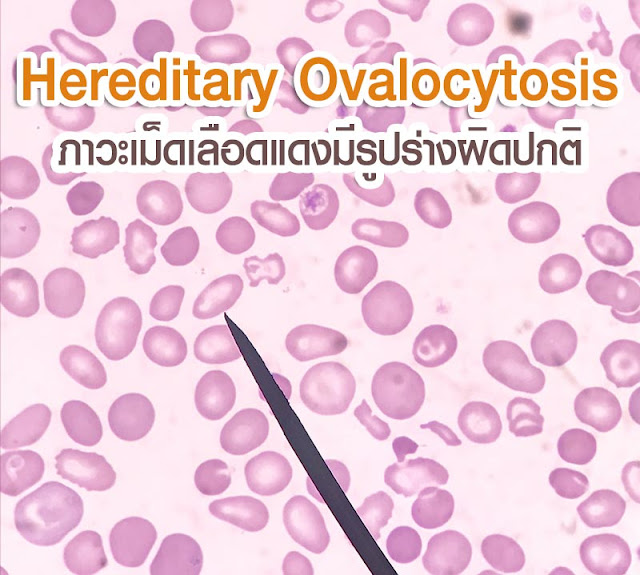
My Image 20

รายการ ภาพถ่ายเกี่ยวกับโรคบุคลิกภาพผิดปกติ ที่เว็บไซต์ cleverlearn-hocthongminh.edu.vn รวบรวมและจัดทำอย่างดีเยี่ยมค่ะ นอกจากนี้ยังมีภาพถ่ายที่เกี่ยวข้องกับ โรคบุคลิกภาพผิดปกติ, ดาวน์โหลด แผ่นพับ โรค ต่า��ๆ, ประภารัตน์ โคกแก้ว, สินค้าอุปโภคบริโภค, บริษัท ปลูกผักเพราะรักแม่ จํากัด โอ้กะจู๋, ปรสิต เพื่อนรักเขมือบโลก ภาค 1, โน๊ ต บุ๊ค เล็ก พก พา, สินค้า อุปโภค บริโภค คือ ซึ่งมีรายละเอียดเพิ่มเติมให้ดูที่ด้านล่างค่ะ
โรคบุคลิกภาพผิดปกติ










.jpg)

.jpg)























ขอขอบคุณสำหรับการดูบทความ โรคบุคลิกภาพผิดปกติ ที่ cleverlearn-hocthongminh.edu.vn ค่ะ คุณสามารถแสดงความคิดเห็น และดูบทความที่เกี่ยวข้องเพิ่มเติมด้านล่างค่ะ หวังว่าจะช่วยเสริมสร้างข้อมูลที่น่าสนใจให้กับคุณค่ะ
Posts: โรคบุคลิกภาพผิดปกติ
Categories: อัลบั้ม
Author: cleverlearn-hocthongminh.edu.vn








